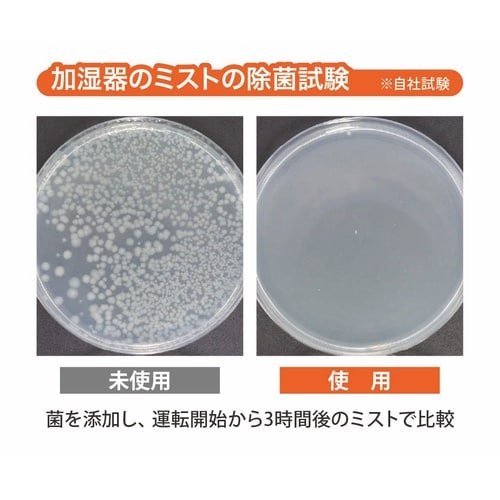
加湿器さぷり

スポットエアコンの売れ筋ランキング
- ¥2,180(税込) (税込) 〜
- ¥2,090(税込) (税込)
- ¥5,480(税込) (税込) 〜
4位
エアーウイング
- ¥3,278(税込) (税込) 〜
- ¥2,178(税込) (税込)
- ¥1,815(税込) (税込) 〜
- ¥81,980(税込) (税込) 〜
商品の特徴 |
自然由来成分100%の抗菌性アミノ酸とビタミンCのチカラで、加湿器や空気清浄機のタンクを除菌し清潔を保ちます。 |
|---|---|
商品仕様 |
|
メーカー情報 |
|
カタログ掲載ページ |
-/- |
| 注意事項 | ※【返品に関するご注意】この商品は直送品のため、お客様のご都合による返品はお受けできません。 |
|---|